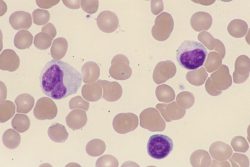
Моноцитарная ангина: особенности течения

Трахея: строение и функции
Трахея – непарный полый орган, который является продолжением гортани и началом нижних дыхательных путей. Она имеет вид длинной цилиндрической трубки, залегающей в нижнем отделе шеи и верхней части грудной клетки. В нижней части трахея перегородкой (шпорой) разделяется на два главных бронха. Это место принято называть зоной бифуркации. Здесь перегородка трахеи несколько смещается влево, при этом […]
Читать далее